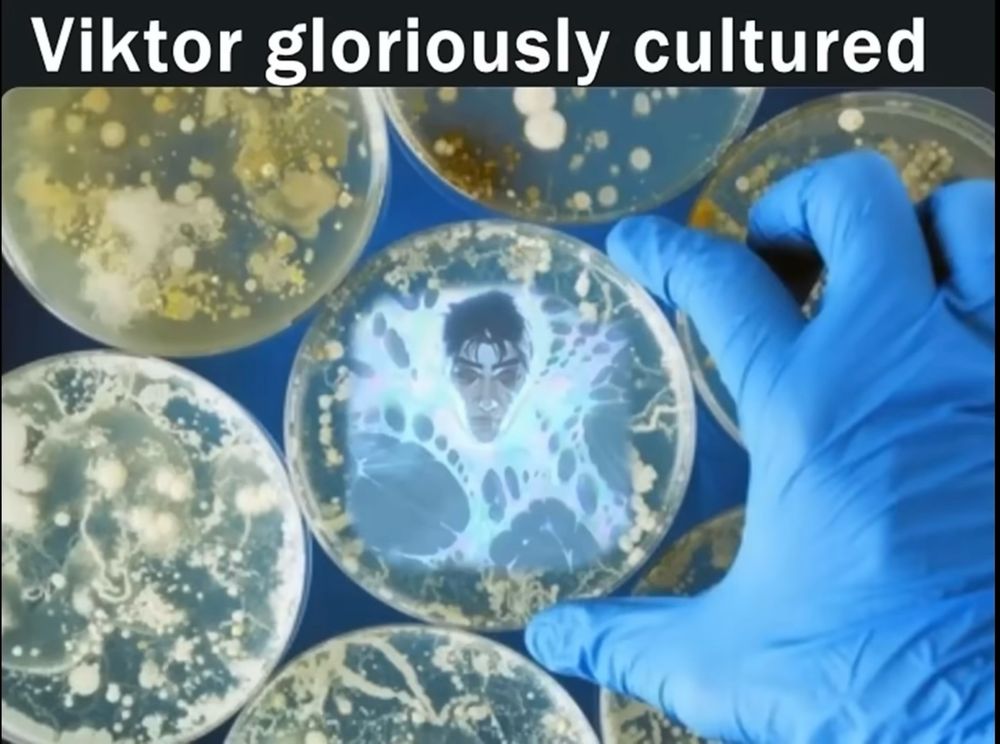

- Stellaris/Europa Universalis IV/CK3
- Pokémon
- Hades
- Baldur’s Gate
- League of Legends (SG/EUW/EUNE)
- Northgard
- Minecraft
- Disco Elysium
- Fallout/Skyrim
- Cyberpunk 2077
- Apex Legends
Ānyttige þis eft, ic bidde.

- Stellaris/Europa Universalis IV/CK3
- Pokémon
- Hades
- Baldur’s Gate
- League of Legends (SG/EUW/EUNE)
- Northgard
- Minecraft
- Disco Elysium
- Fallout/Skyrim
- Cyberpunk 2077
- Apex Legends
Ānyttige þis eft, ic bidde.